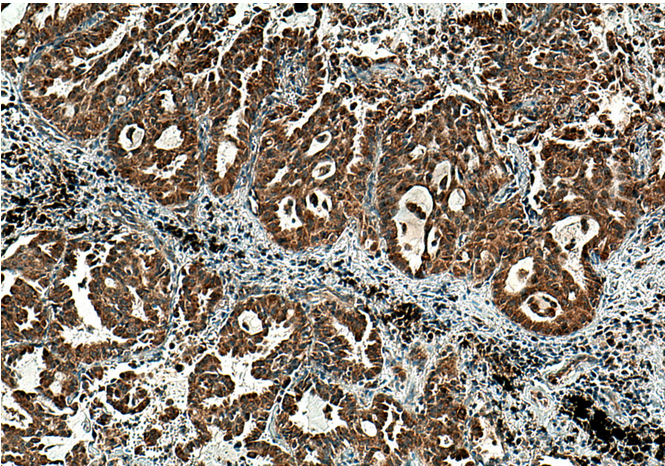
image

| WB | 1:1000-1:8000 | human, mouse, rat |
| IHC | 1:50-1:500 | human, mouse, rat |
| IF/ICC | 1:200-1:800 | human, mouse, rat |
| 宿主/亚型 | Rabbit / IgG |
| 抗体类别 | Polyclonal |
| 产品类型 | Antibody |
| 全称 | phosphoserine aminotransferase 1 |
| 别名 | EPIP, Phosphoserine aminotransferase, PSA, PSAT, PSAT1 |
| 计算分子量 | 370 aa, 40 kDa |
| 观测分子量 | 37-40 kDa |
| GenBank蛋白编号 | BC001618 |
| 基因名称 | PSAT1 |
| Gene ID (NCBI) | 29968 |
| RRID | AB_10665948 |
| 偶联类型 | Unconjugated |
| 形式 | Liquid |
| 纯化方式 | Antigen affinity purification |
| UNIPROT ID | Q9Y617 |
| 储存缓冲液 | PBS with 0.02% sodium azide and 50% glycerol, pH 7.3. |
| 储存条件 | Store at -20°C. Stable for one year after shipment. |
Immunohistochemical analysis of paraffin-embedded human lung cancer tissue slide using PSAT1 antibody at dilution of 1:200 (under 10x lens). Heat mediated antigen retrieval with Tris-EDTA buffer (pH 9.0).

Immunofluorescent analysis of (4% PFA) fixed HepG2 cells using PSAT1 antibody at dilution of 1:400 and CoraLite®488-Conjugated Goat Anti-Rabbit IgG(H+L).
×